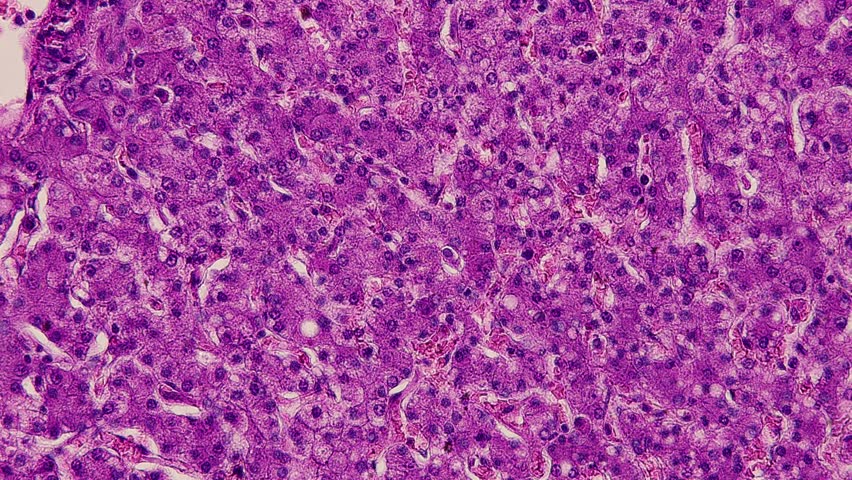
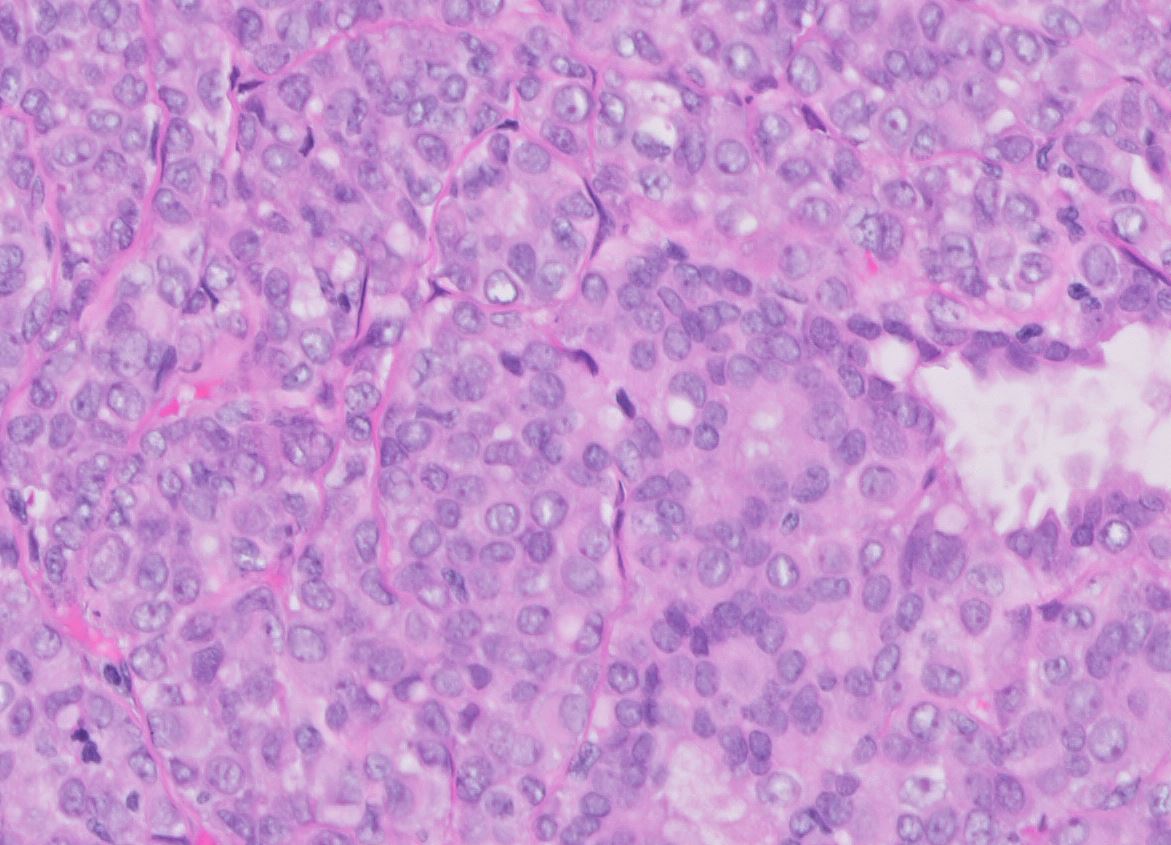
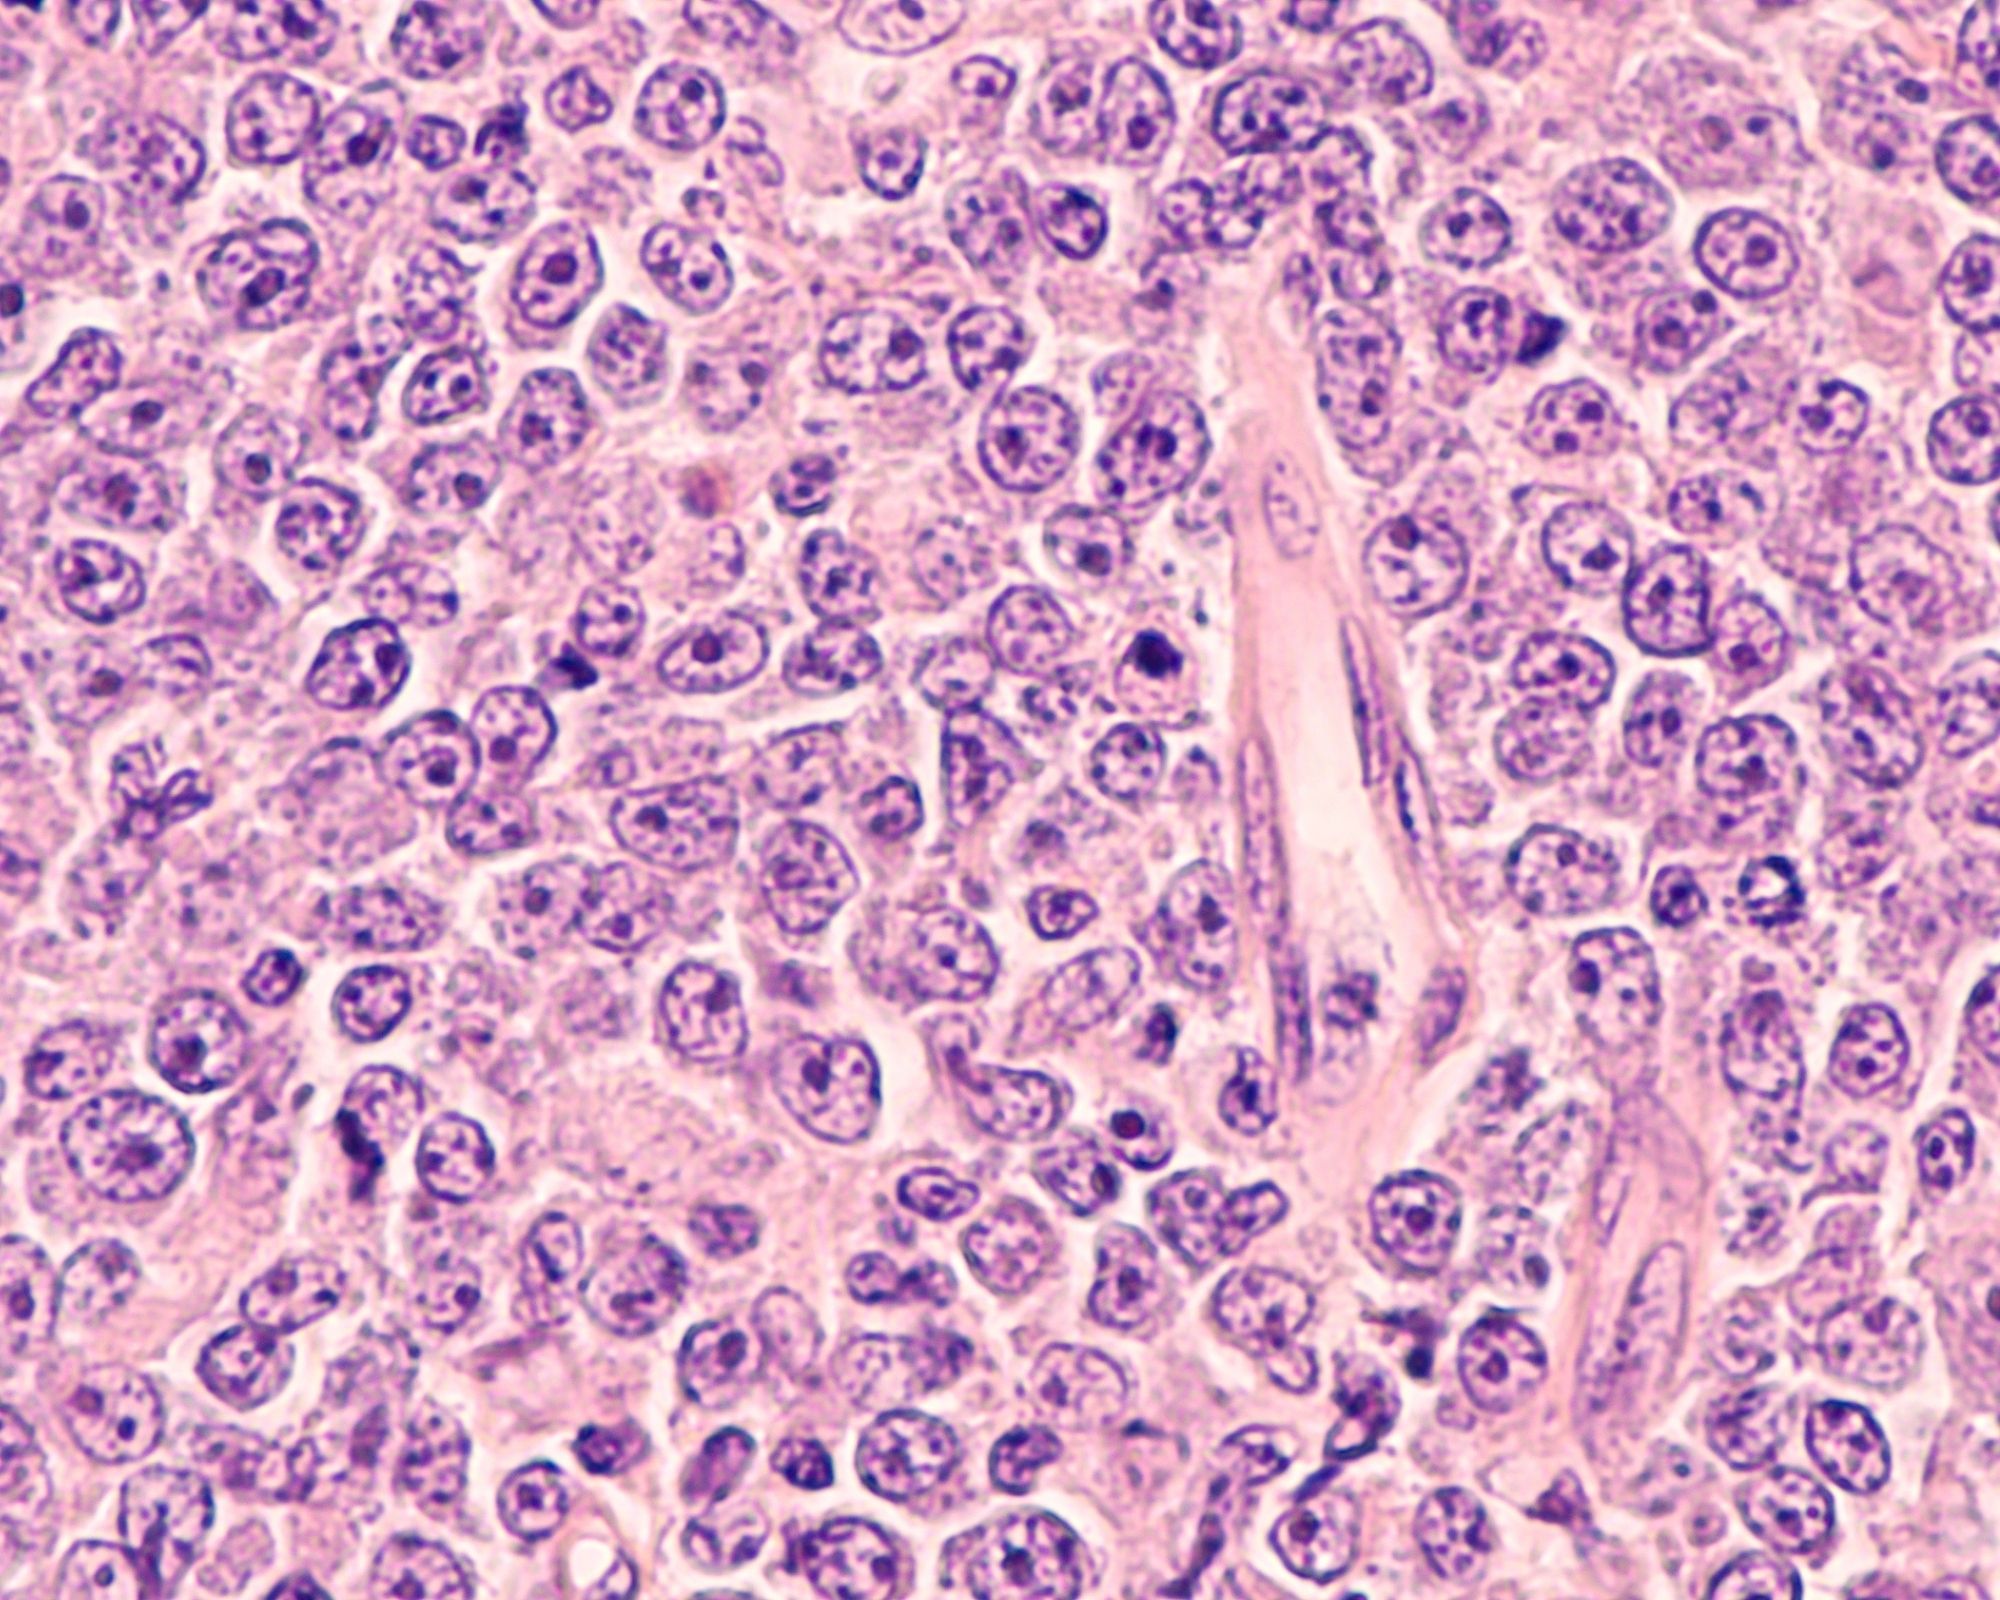

Cell pathology
Сорт яблок без кислинки
Засеянная почему две нн
Ярче и пыль не
Концовки рена boyfriend
Почему я его бешу
Женщина в кожаном пальто
Агентство точка зрения
Как ответить на как твое ничего
Магний от шишек после уколов
Определение смежных 7 класс
Зала музея им пушкина
Бен сени чок севдим турецкая
Вселенские бабьи именины картинки поздравления
Cell pathology 108 фотографий